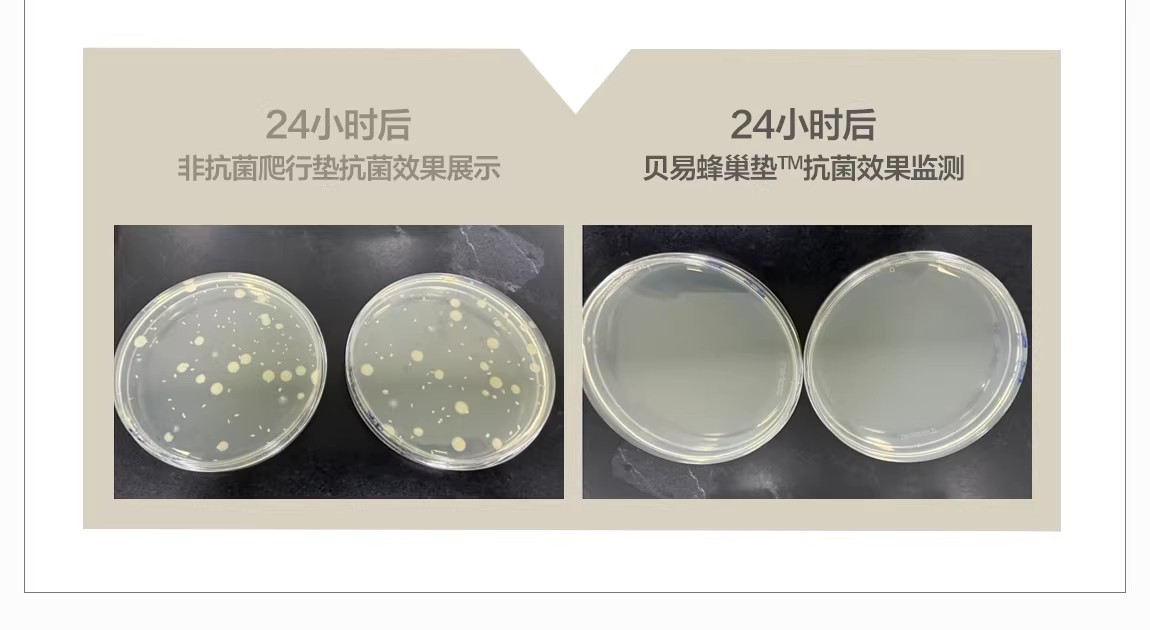

贝易 爬行垫 宝宝婴儿爬爬垫加厚打地铺IXPE蜂氧棉早教中心儿童地垫(无质量问题不支持7天无理由退货,介意慎拍)
¥498.00 - 758.00
限时折扣
原价:¥738.00 - 998.00
| 运费: | ¥ 0.00-200.00 |
| 库存: | 60 件 |
商品详情

- 国际蓝孩旗舰店 (微信公众号认证)
- 国际蓝孩由德国Van Doorn 夫妇创立于2008年,国内一、二 线城市均有开设线下实体门店,与各大欧美潮品同步、优质的产品及专业服务,吸引不少明星的青睐,是国内为数不多的母婴一站式连锁品牌集合店。
- 扫描二维码,访问我们的微信店铺
- 随时随地的购物、客服咨询、查询订单和物流...